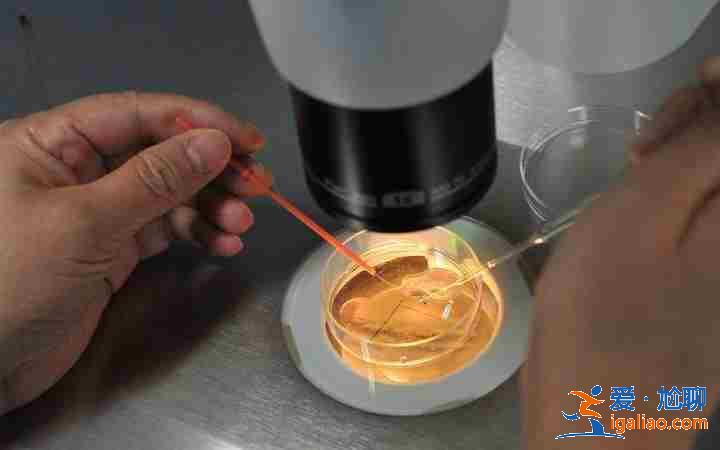
代媽的價(jià)位,(誠信服務(wù))-? 代媽的價(jià)位,(誠信服務(wù))-?

代媽的價(jià)位,(誠信服務(wù))-?
代媽的價(jià)位,(誠信服務(wù))-,AA69助孕為那些不孕不育家庭提供優(yōu)質(zhì)的助孕服務(wù),AA69助孕是中國合法正規(guī)專業(yè)的AA69助孕服務(wù)網(wǎng)站,是經(jīng)得起考驗(yàn)的助孕公司
試管嬰兒不是試管里生長的嬰兒,而是從卵巢中取出的幾個(gè)卵子,再結(jié)合男人的精子形成胚胎。主要生長在子宮內(nèi),然后像正常懷孕的寶寶一樣。

試管成功后飲食方面有哪些要注意
精子活力可以提高嗎,怎樣增加精子活力?
精子活力是可以提高的,只是需要男性補(bǔ)充一些生育酚成分的食物。當(dāng)然怕麻煩的話,可以試試康爸爸,效果是一樣的。
哪些情況下符合進(jìn)行試管嬰兒治療?
適合做試管嬰兒的女性,較多本身患有嚴(yán)重輸卵管相關(guān)的疾病。如異位妊娠術(shù)或者盆腔炎導(dǎo)致的輸卵管堵塞、積水;子宮內(nèi)膜正常但輸卵管結(jié)核;卵泡不破裂綜合征;子宮內(nèi)膜異位癥及等。不過既然選擇試管嬰兒治療,就要抱有一定的信心,這樣也能夠增加試管嬰兒的成功幾率。
我們的服務(wù)優(yōu)勢(shì):
你好,試管嬰兒主要是針對(duì)不孕不育夫婦,可以輔助受孕。做試管嬰兒前多吃一些含鋅的食物,注意補(bǔ)充營養(yǎng),提高精子質(zhì)量,建議你服用精活速,融合十余種對(duì)精子有重要意義的物質(zhì),全面提升精子質(zhì)量、正常形態(tài)精子數(shù)量、活動(dòng)力、精液量、精液液化等精子指標(biāo),可以顯著改善男性精子質(zhì)量,受孕率提高12倍提高試管嬰兒的成功率
以上是對(duì)“試管嬰兒的好處有哪些?”這個(gè)問題的建議,希望對(duì)您有幫助,祝<愛尬聊_頭條百科>您健康!
做試管嬰兒的具體流程步驟
胚胎的發(fā)育過程
卵裂期胚胎
受精后24~36小時(shí),受精卵分裂為兩個(gè)細(xì)胞,受精后72小時(shí),分裂為6~8個(gè)細(xì)胞。一般受精后第三天移植的是卵裂球期的胚胎。
卵裂期胚胎的細(xì)胞繼續(xù)分裂,細(xì)胞間逐漸出現(xiàn)小的腔隙,大約2天后它們最后匯合成一個(gè)大腔,桑椹胚轉(zhuǎn)變?yōu)橹锌盏呐吲荨E吲菀簿褪俏覀兯赖哪遗撸@個(gè)時(shí)候是受精卵發(fā)育的第5~7天。囊胚培養(yǎng)有利于進(jìn)一步篩選出發(fā)育潛能好的胚胎,目前我們中心囊胚形成率約60%,但是有少部分患者會(huì)因?yàn)榕咛]有發(fā)育到囊胚而無法移植。
大部分的情況下,一次取卵周期可以形成好幾個(gè)可移植的胚胎,但每次僅需要移植1~2枚胚胎,那么多余的胚胎就將被保存在-196度的液氮中冷凍起來。因此,根據(jù)胚胎是否進(jìn)行冷凍,又分成“鮮胚”和“凍胚”。

我們來看看大伙比較關(guān)心的問題:
可以促進(jìn)排卵嗎,有專業(yè)的醫(yī)療人士嗎?
如果試過蘿卜試紙,就知道這里有專家,可以一對(duì)一的私人定制備孕指導(dǎo),也知道如何安全有效地促排,是有方法的。
-----------
可以促進(jìn)排卵嗎,我的試紙測(cè)不出?
先試試別的試紙吧,促排不要急,可以吃點(diǎn)大豆之類。換一個(gè)試紙不影響身體,促排就不一定了。試紙的話,推薦試試蘿卜試紙,更準(zhǔn)確,靈敏度更高。
-----------
排卵有幾天啊,周期是穩(wěn)定的嗎?
排卵周期一般是7天左右,周期時(shí)間有個(gè)大概范圍,會(huì)有所波動(dòng)。但是可以用蘿卜試紙,測(cè)一下具體的排卵期,是沒有問題的。
-----------
子宮內(nèi)膜異位癥檢查需要注意什么呀?
專家建議:子宮內(nèi)膜異位癥的檢查方法,早期的子宮內(nèi)膜異位癥是做腹腔鏡的探討才發(fā)現(xiàn)的,比如形成的巧克力囊腫,通過B超可以診斷,還有子宮腺肌癥,通過B超和MRI都可以診斷出來。而有些患者是有癥狀的,在出現(xiàn)癥狀之后要及時(shí)進(jìn)行檢查, 及早擁異位婦善坊帖治療。
【三代試管嬰兒助孕】【愛心助孕】【上萬成功案例】【專業(yè)公司】【2021最新價(jià)格】
今天的內(nèi)容就介紹到這里,更多關(guān)于代媽的價(jià)位,(誠信服務(wù))-的內(nèi)容,詳情可咨詢呂進(jìn)峰助孕機(jī)構(gòu)顧問-微電同步!
